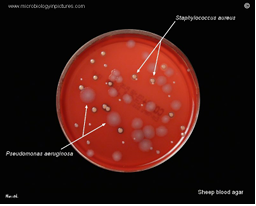

Microbial Keratitis and Peripheral Corneal Changes/Ulcerations
Microbial Keratitis and Peripheral Corneal Changes/Ulcerations
Peripheral Corneal Changes/Ulcerations
Dellen
Marginal keratitis
Rosacea
Phlyctenular disease
Terrien’s marginal degeneration
Microbial Keratitis
Bacterial
Viral
Fungal
Acanthamoeba
Interstitial
Microbial Keratitis – Terminology
Also called:
Corneal infection
Infectious keratitis
Corneal ulceration
Ulcerative keratitis
Suppurative keratitis
Microbial Keratitis
Clinical Definition:
Presumed infection of the cornea by replicating microbes.
Characterized by excavation of the corneal epithelium, Bowman’s layer, and stroma with infiltration and necrosis of the tissue.
Requires treatment with topical antibiotics.
Sight threatening; requires immediate referral.
Symptoms
Pain
Discharge: watering and/or mucopurulent
Photophobia
Lid oedema
Signs
Severe generalised conjunctival hyperemia
Corneal oedema
Dense central and/or mid-peripheral stromal infiltration
Epithelial & stromal erosion
Anterior chamber reaction/ hypopyon
ciliary flush (not in conjunctivitis)


MK Incidence
Rare: Annual incidence of MK:
0.63 per 10,000 (Hong Kong, Lam et al, 2002)
0.36 per 10,000 (Scotland, Seal et al, 1999)
reason for low incidence → cornea has tight junction in epithelium and prevent pathogens entering, tears have antimicrobial and antibacterial material. → these work together to defend eye against infection.
Causes
Review of 291 patients (casualty and in-patient) over 2 years at RVEEH, Melbourne (Keay, Edwards et al, 2006):
Trauma: 37%
Contact lens: 34%
Unknown: 8%
Ocular Surface Disease (OSD): 6%
Systemic: 2%
Herpetic: 7%
Multifactorial: 6%
do not need to remember percentages.
MK - Causative Organisms
Table 2. Organisms Isolated in Microbial Keratitis Cases (Excluding Presumed Herpetic Keratitis, n = 246)
Gram-positive bacteria
Staphylococcus aureus
Coagulase-negative Staphylococcus
Streptococcus pneumoniae
Other Streptococcus species
Corynebacterium species
Propionibacterium species
Gram-negative bacteria
Mixed gram-negative rods
Pseudomonas aeruginosa
Serratia species
Haemophilus influenzae
Other enteric species
Other nonenteric species
Amoeba
acanthamoeba
Fungal
Filamentous fungi
Candida albicans
Sterile samples
ocular surface → gram positive
ocular trauma → fungal disease
Microbial Keratitis - Causes
Bacterial
Viral
Herpes simplex
Herpes zoster
Fungal
Acanthamoeba
Interstitial
Bacterial Keratitis
Signs/Symptoms
Pain, photophobia, lacrimation
Mucopurulent discharge
Redness (ciliary flush)
AC cells, possibly KP or hypopyon


Pseudomonas keratitis
Pseudomonas aeruginosa
Virulent and common (esp CL)
Usually central and rapid
More difficult to treat and worse prognosis than other bacterial keratitis
Potential necrotic liquefication of the cornea (rapid K weakening and perforation) due to protease secretion.
“melting of cornea”
Bacterial Keratitis - Treatment
Antibiotics
NO STEROIDS (to begin with)
Cycloplegic if required (and oral analgesia)
Hospital admission if unable to comply with Tx
Corneal scraping - start antibiotics before results return (~50% scraps will come back sterile)
Loading dose:
Topical fluoroquinolones (ciprofloxacin or ofloxacin) Q1h for 2 days
ciprofloxacin = hot climates
ofloxacin = cool climates
If good response, QID until completely resolved
Steroid after 2-3 days of progressive improvement (FML acetate) to limit scarring
Viral Keratitis
Herpes Simplex (HSV-1)
Acute follicular conjunctivitis
Skin blister
mild watery discharge (compared to bacterial mucopurulent)
Fine coarse keratitis
Dendritic lesions (terminal end bulbs)
Geographic ulcer
Reduced corneal sensitivity

Recurrence
Poor health
Sun
Fever
Mild trauma
Menstruation
Psychiatric problems/emotional stress
Topical or systemic steroids
Prophylactic oral acyclovir
Treatment
Antiviral- 3% Acyclovir ointment
1cm ribbon in inferior fornix
5x day for 14 days or 3 days after healing
Cycloplegic for pain management
Rapid referral for stromal and endothelial involvement
Herpes Zoster Ophthalmicus
Virus in the trigeminal ganglion involving branches of the ophthalmic division
Unilateral, usually in middle aged to elderly people
Signs:
Painful, erythematous and blistered forehead
If lesions to tip of nose, eye complications likely (Hutchinson’s sign)
Cornea:
Subepithelial opacities
Dendriform-like lesions (sharp edges) and deeper stromal infiltrates
Iridocyclitis
Corneal anaesthesia
Lid oedema

Cranial Nerve 5 (CNV)
CNV1: Ophthalmic Nerve (V1)
CNV2: Maxillary Nerve (V2)
CNV3: Mandibular Nerve (V3)

Treatment:
EARLY oral Acyclovir 800mg 5 times a day for 5 days (within 72 hrs of start of rash)
OR: Valacyclovir (1g PO q8h for 7 days) OR famcyclovir (250mg PO q8h for 7 days)
Atropine and steroids for uvea
Tarsorrhaphy if cornea is very anaesthetic
Contagious during the vesicular stage (patient should avoid people who haven't had chicken pox and pregnant women)
Herpetic Infections - Posterior Segment
May also involve the posterior segment.
Acute retinal necrosis is rare but devastating.
DILATE!
If retinal lesions or vitreous haze are noted, same-day referral is essential.
Fungal Keratitis
Rare
Commonly caused by:
Contact with vegetable matter (Filamentous)
Hx of ocular surface disease or prolonged use of topical steroids (Candida)
Signs/Symptoms:
Grey-white indistinct lesions with feathery projections
Multiple satellite foci
Treatment
Destructive and difficult to treat (high Tx failure rate)
Refer
Hospital
Topical Natamycin 5% first agent of choice

Acanthamoeba Keratitis
Freshwater amoeba
Brackish water, wearing contact lenses while swimming, poor CL hygiene (tap water), exposure to pool/spa water with corneal abrasion
Signs/Symptoms:
PAIN!!!
Keratitis - but degree of pain exceeds the signs
Early signs can be subtle (irregular greyish epithelial keratitis, focal stromal infiltrates, perineural infiltrates - adjacent to or along a nerve)
Ring infiltrate
Treatment:
Refer IMMEDIATELY
Diagnosis difficult, but important.
confocal microscopy image.
Topical neosporin, chlorhexidine, polyhexamethylene (PHMB), propamidine (Brolene)
Cycloplegic
Treatment can continue for months (very resistent to treatment)

Interstitial Keratitis
Rare
Caused by: congenital syphilis (most common), herpes, mycobacteria (TB)
Signs/Symptoms:
Redness, photophobia, pain and lacrimation (acute phase)
Active inflammation within the corneal stroma
Stromal vascularisation and oedema
AC cells and KP
Deep stromal scarring and ghost vessels
Treatment:
Topical steroids - dappen immune response
Cycloplegia - pain management
Address the underlying cause